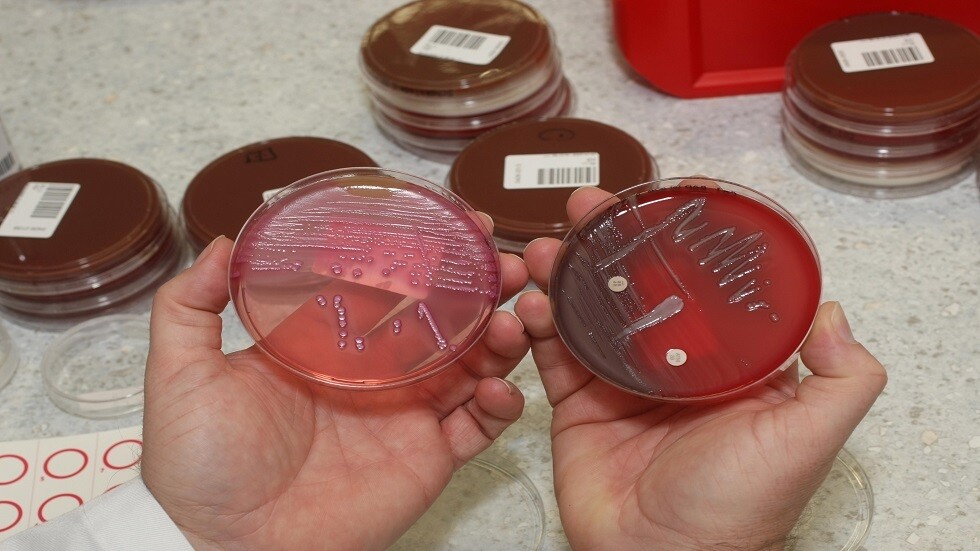
اكتشاف بكتيريا في الأمعاء تؤثر في تراكم السموم في الدم

Stories
-
هدنة وحصار المضيق
RT STORIES
أكسيوس: ترامب يرفض عرض إيران
#اسأل_أكثر #Question_MoreRT STORIES
مسؤول في البنتاغون: الحرب على إيران كلفت 25 مليار دولار حتى الآن
#اسأل_أكثر #Question_MoreRT STORIES
مصدر إسرائيلي: ترامب يفقد الثقة بإسرائيل
#اسأل_أكثر #Question_MoreRT STORIES
بيسينت: قمنا بمصادرة نحو 500 مليون دولار من الأصول الإيرانية
#اسأل_أكثر #Question_MoreRT STORIES
ترامب يهدد إيران حاملا البندقية: لن أكون لطيفا أكثر بعد اليوم
#اسأل_أكثر #Question_MoreRT STORIES
رويترز تتحدث عن تراتبية "سلطة الحرب" في إيران
#اسأل_أكثر #Question_MoreRT STORIES
بروجردي لترامب: لن نتركك وشأنك وسيطرتنا على مضيق هرمز أبدية
#اسأل_أكثر #Question_MoreRT STORIES
ترامب يستقر على خيار بشأن مستقبل المواجهة مع إيران
#اسأل_أكثر #Question_MoreRT STORIES
إيران لحظة بلحظة.. ضبابية في واشنطن وارتباك بتل أبيب ومساع روسية وخليجية لصياغة تسوية شاملة
#اسأل_أكثر #Question_MoreRT STORIES
ارتباك إسرائيلي وحيرة.. غموض مواقف ترامب يربك حسابات تل أبيب تجاه العرض الإيراني
#اسأل_أكثر #Question_More
هدنة وحصار المضيق
-
العملية العسكرية الروسية في أوكرانيا
RT STORIES
وزير الحرب الأمريكي: ترامب يؤمن بإمكانية التوصل إلى صفقة سلام بين روسيا وأوكرانيا
#اسأل_أكثر #Question_MoreRT STORIES
رئيس هيئة الأركان الأمريكية: النزاع الأوكراني مكن روسيا من "إعادة هيكلة وتحديث" قواتها القتالية
#اسأل_أكثر #Question_MoreRT STORIES
في اتصال مع ترامب.. بوتين يبحث هدنة مؤقتة في أوكرانيا ويؤكد أن أهداف العملية العسكرية ستتحقق
#اسأل_أكثر #Question_MoreRT STORIES
ترامب: أوكرانيا منيت بهزيمة عسكرية
#اسأل_أكثر #Question_MoreRT STORIES
بوتين خلال استقبال قديروف: أكثر من 71 ألف شخص من الشيشان يشاركون في العملية العسكرية في أوكرانيا
#اسأل_أكثر #Question_MoreRT STORIES
الكرملين: سيتم الإعلان عن مواعيد هدنة "يوم النصر" قريبا
#اسأل_أكثر #Question_MoreRT STORIES
زاخاروفا: أوروبا تخاطر بأن تصبح الضحية الأولى لابتزاز زيلينسكي النووي
#اسأل_أكثر #Question_MoreRT STORIES
مقاطعة سومي.. مشاهد لمعارك تحرير بلدة نوفودميتروفكا
#اسأل_أكثر #Question_MoreRT STORIES
الدفاع الروسية تعلن تحرير بلدة جديدة شمال أوكرانيا
#اسأل_أكثر #Question_MoreRT STORIES
روسيا.. اعتقال عميل أوكراني خطط لأعمال إرهابية في القرم
#اسأل_أكثر #Question_MoreRT STORIES
بوتين يحذر: الضربات الأوكرانية على توابسي تهدد بكارثة بيئية
#اسأل_أكثر #Question_MoreRT STORIES
بوتين: كييف تخسر كل يوم أراض في منطقة العملية العسكرية الخاصة
#اسأل_أكثر #Question_MoreRT STORIES
القوات الروسية تدخل "دولغايا بالكا" بعد تحرير إيلينوفكا وبدء تطويق قسطنطينوفكا
#اسأل_أكثر #Question_More
العملية العسكرية الروسية في أوكرانيا
-
هدنة بين حزب الله وإسرائيل
RT STORIES
الرئيس اللبناني: إذا اعتقدت إسرائيل أنها بالتدمير ستحصل الأمن فهي مخطئة.. جربت ذلك قبلا دون نتيجة
#اسأل_أكثر #Question_MoreRT STORIES
كيف يستغل "حزب الله" سلاحه الاستراتيجي الجديد؟ ضابط إسرائيلي رفيع يثير المخاوف ويستبعد الحلول
#اسأل_أكثر #Question_MoreRT STORIES
تل ابيب تبلغ واشنطن رسميا: الردع الإسرائيلي ينهار ويتآكل أمام حزب الله
#اسأل_أكثر #Question_MoreRT STORIES
أكسيوس: ترامب يطلب من نتنياهو شن ضربات "جراحية" فقط في لبنان وتجنب العودة للحرب الشاملة
#اسأل_أكثر #Question_MoreRT STORIES
مسؤول لبناني يكشف عن تكلفة الحرب الباهظة
#اسأل_أكثر #Question_MoreRT STORIES
الجيش اللبناني يعلن مقتل جندي وشقيقه باستهداف إسرائيلي
#اسأل_أكثر #Question_MoreRT STORIES
الجيش الإسرائيلي يكرس مصطلح "خط الدفاع الأمامي" ويهاجم "حزب الله" في جنوب لبنان (فيديو)
#اسأل_أكثر #Question_MoreRT STORIES
لبنان لحظة بلحظة.. تلويح إسرائيلي بمعاملة الجنوب كغزة وحزب الله يصعد هجماته بالمسيرات
#اسأل_أكثر #Question_MoreRT STORIES
وزير الدفاع الإسرائيلي: جنوب لبنان سيعامل كغزة
#اسأل_أكثر #Question_MoreRT STORIES
مكتب رئيس مجلس النواب اللبناني: لسنا مع التفاوض المباشر والثقة بين بري وجماهيره راسخة
#اسأل_أكثر #Question_More
هدنة بين حزب الله وإسرائيل
-
نبض الملاعب
RT STORIES
رونالدو يقود النصر للفوز على الأهلي والاقتراب من لقب الدوري السعودي
#اسأل_أكثر #Question_MoreRT STORIES
أتلتيكو مدريد وأرسنال يفترقان على التعادل في ذهاب نصف نهائي دوري الأبطال
#اسأل_أكثر #Question_MoreRT STORIES
باريس سان جيرمان يكشف طبيعة إصابة حكيمي ويؤكد غيابه عن مواجهة بايرن
#اسأل_أكثر #Question_MoreRT STORIES
إيقاف حارس مرمى سرقسطة 13 مباراة بعد اعتدائه على لاعب منافس
#اسأل_أكثر #Question_MoreRT STORIES
الاتحاد العالمي للملاكمة يسمح للملاكمين الروس بالمشاركة في بطولاته محايدين
#اسأل_أكثر #Question_MoreRT STORIES
إدانات روسية لتصريحات أسطورة كرة القدم الأوكرانية
#اسأل_أكثر #Question_MoreRT STORIES
تتويج ملاكم روسي بطلا للعالم بعد نزال مثير للجدل في تركيا
#اسأل_أكثر #Question_MoreRT STORIES
إنفانتينو يعد بدعم شامل لكرة القدم السورية
#اسأل_أكثر #Question_MoreRT STORIES
محكمة التحكيم الرياضي تحدد موعد رد المغرب في نزاع كأس أمم إفريقيا 2025
#اسأل_أكثر #Question_MoreRT STORIES
فيفا يقر زيادة تاريخية في مكافآت كأس العالم 2026
#اسأل_أكثر #Question_MoreRT STORIES
تصعيد قانوني فلسطيني ضد فيفا بسبب أندية المستوطنات
#اسأل_أكثر #Question_MoreRT STORIES
صدفة أم قرار رسمي.. ظهور علم إيطاليا في سياتل يثير الجدل حول دخولها كأس العالم بدلا من إيران!
#اسأل_أكثر #Question_MoreRT STORIES
من الأولمبياد إلى "القائمة السوداء".. إدراج متزلجين روسيين في موقع "ميروتفوريتس" النازي
#اسأل_أكثر #Question_MoreRT STORIES
"قانون فينيسيوس".. "الفيفا" يقر قاعدة جديدة في كأس العالم 2026
#اسأل_أكثر #Question_MoreRT STORIES
إستاد مصر يتأهب لقمة عالمية بين منتخبي مصر وروسيا استعدادا للمونديال
#اسأل_أكثر #Question_More
نبض الملاعب
-
فيديوهات
RT STORIES
مصارع مصري يخطف الأنظار بحركة مبهرة
#اسأل_أكثر #Question_MoreRT STORIES
الجيش الإسرائيلي يعلن عن القضاء على رئيس قسم العمليات في هيئة الاستخبارات لحركة "حماس"
#اسأل_أكثر #Question_Moreفيديوهات
أخصائي روسي يحذر من خطورة "أوميكرون" على الأطفال!
أشار اختصاصي الوبائيات الروسي، أندريه بوزدنياكوف إلى أن متحور "أوميكرون" يتكاثر بسهولة أكثر في الشعب الهوائية، مقارنة بمتحور "الدلتا" ونادرا ما ينزل إلى الرئتين.
وقال الأخصائي في حديث أدلى به يوم 17 يناير إن متحور "أوميكرون" يعد أكثر خطورة على الأطفال، لأنه يسبب التهاب الشعب الهوائية مع مضاعفات خطيرة.
وأضاف قائلا:" ينقل الأطفال إلى المستشفى مع "أوميكرون" في معظم الأحيان بسبب خصوصيته حيث تتكاثر هذه السلالة بسهولة في القصبات الهوائية وتواجه صعوبة في التكاثر داخل الرئتين، مقارنة بسلالة "الدلتا". ويدل ذلك على أنها تسبب التهاب الشعب الهوائية، وليس الالتهاب الرئوي".
اكتشاف بكتيريا في الأمعاء تؤثر في تراكم السموم في الدم
وحسب بوزدياكوف، فأن ذلك يعتبر أمرا جيدا إلى حد ما للبالغين، لأن التهاب الشعب الهوائية، خلافا للالتهاب الرئوي، أمر مزعج ، لكنه ليس مميتا. ومع ذلك، فإن الوضع يختلف عند الأطفال نظرا لسماتهم الوظيفية المرتبطة بالعمر، وغالبا ما يؤدي التهاب الشعب الهوائية لديهم إلى مضاعفات خطيرة.
"وأوضح قائلا:" إن القصبات الهوائية عند المراهقين، شأنهم شأن البالغين، قد تكوّنت تقريبا، بينما يختلف الأمر لدى الأطفال الصغار. فكلما كان الطفل أصغر، كان تجويف الشعب الهوائية أضيق، وزاد ثراء الأوعية الدموية، وإمدادات الدم لديها."
ومع تطوّر التهاب الشعب الهوائية، يتم إغلاق التجويف بشكل أسرع، كما يتم إفراز المزيد من المخاط، وعلى خلفية الأوعية الدموية الغنية، ينتشر المرض بشكل أسرع.
وأضاف الأخصائي أن التهاب القصيبات، باعتباره من المضاعفات الشائعة لمرض التهاب الشعب الهوائية، هو التهاب في أجزاء صغيرة من الشعب الهوائية، يمكن أن يكون مصحوبا بفشل تنفسي حاد ويؤدي إلى نتائج غير مرجوة، مشيرا إلى أن هذا الأمر لم يتم تسجيله في حال الإصابة بسلالات أخرى.
المصدر: لايف
التعليقات